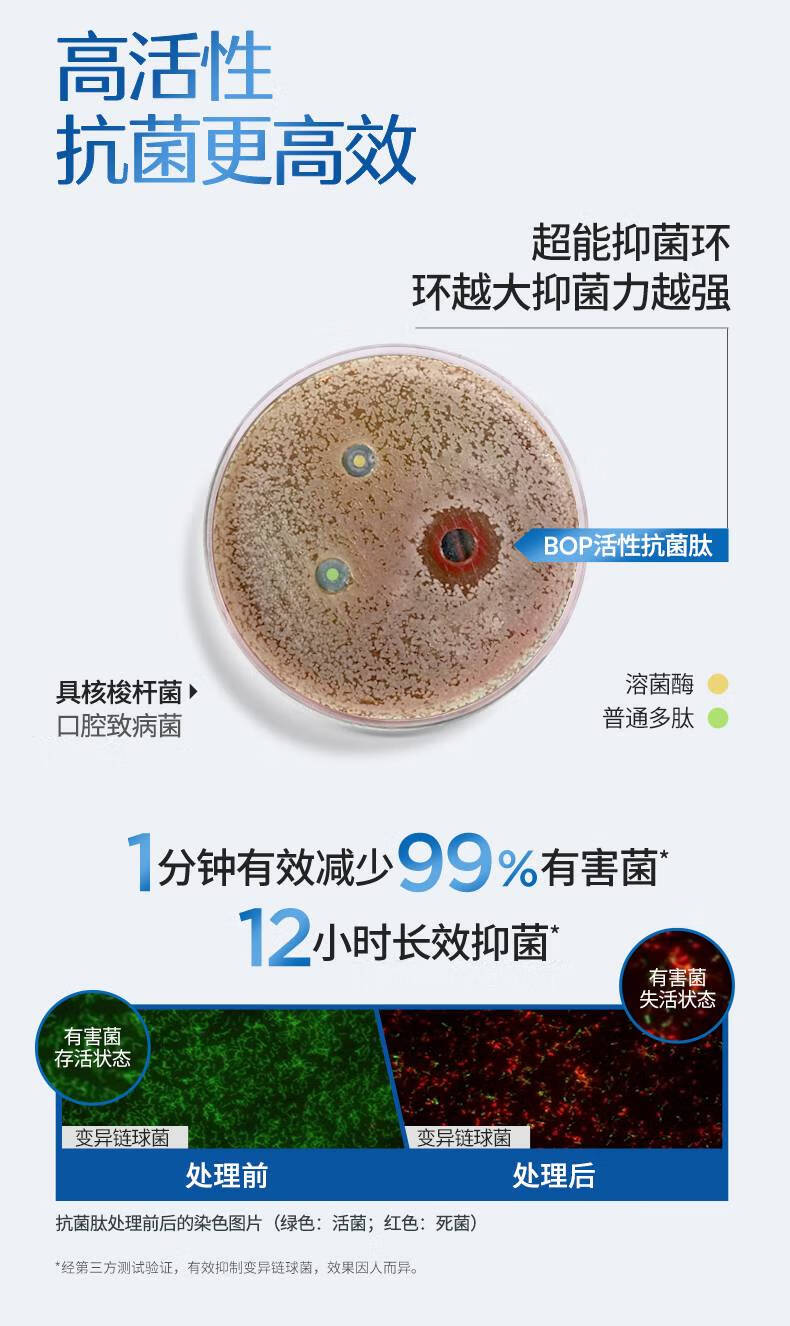

Pop specializes in active antibacterial peptide toothpaste to whiten, freshen breath, repair gums, and improve oral problems such as bad breath. Dissolved whitening 120g*3 pieces. Stock up.
414.56تومان
- Stock: In Stock
- Model: j10168629711281
Create unlimited custom product blocks and display them in accordions or tabs or open blocks. Each block can be assigned to all products at once or specific products according to advanced criteria.
Create unlimited custom product blocks and display them in accordions or tabs or open blocks. Each block can be assigned to all products at once or specific products according to advanced criteria.